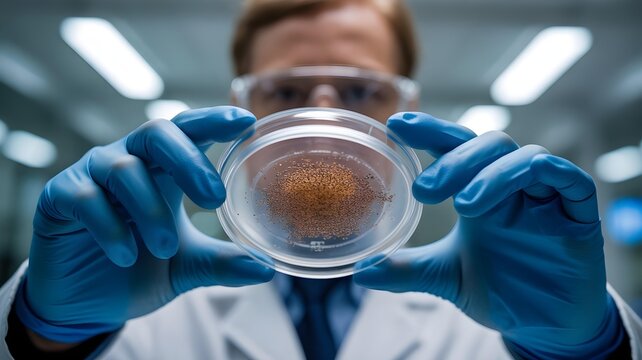
A cinematic close-up of a scientist's hands (wearing gloves) holding a petri dish with a catalyst material for a fuel cell. - Powered by Adobe
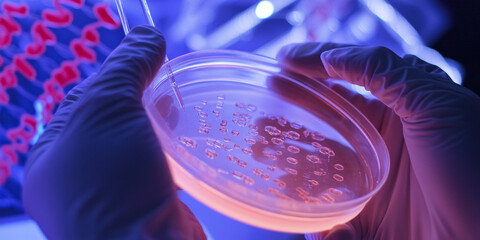
Hands Holding Petri Dish with DNA Background
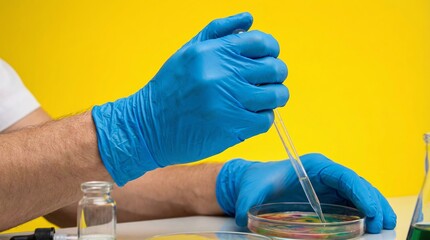
Close up of gloved hands holding glass dropper over petri dish in laboratory

- Home >
- Stock Photos >
- Scientist Holding Seedling Enhancing Greenhouse Growth
Scientist Holding Seedling Enhancing Greenhouse Growth Image

A scientist in a greenhouse holding a green seedling delicately in cupped hands, demonstrating care in cultivation and the eco-friendly nature of agriculture and research. Suitable for depicting innovation in agriculture, sustainability, and scientific research in eco-friendly farming. Ideal for use on websites, educational materials, and promotions about horticulture and growth industries.
0
downloads
downloads
Tags:
More
Credit Photo
If you would like to credit the Photo, here are some ways you can do so
Text Link
photo Link
<span class="text-link">
<span>
<a target="_blank" href=https://pikwizard.com/photo/scientist-holding-seedling-enhancing-greenhouse-growth/982662a54e83b7cd9df6a47a8ce582b1/>PikWizard</a>
</span>
</span>
<span class="image-link">
<span
style="margin: 0 0 20px 0; display: inline-block; vertical-align: middle; width: 100%;"
>
<a
target="_blank"
href="https://pikwizard.com/photo/scientist-holding-seedling-enhancing-greenhouse-growth/982662a54e83b7cd9df6a47a8ce582b1/"
style="text-decoration: none; font-size: 10px; margin: 0;"
>
<img src="https://pikwizard.com/pw/medium/982662a54e83b7cd9df6a47a8ce582b1.jpg" style="margin: 0; width: 100%;" alt="" />
<p style="font-size: 12px; margin: 0;">PikWizard</p>
</a>
</span>
</span>
Free (free of charge)
Free for personal and commercial use.
Author: Creative Art